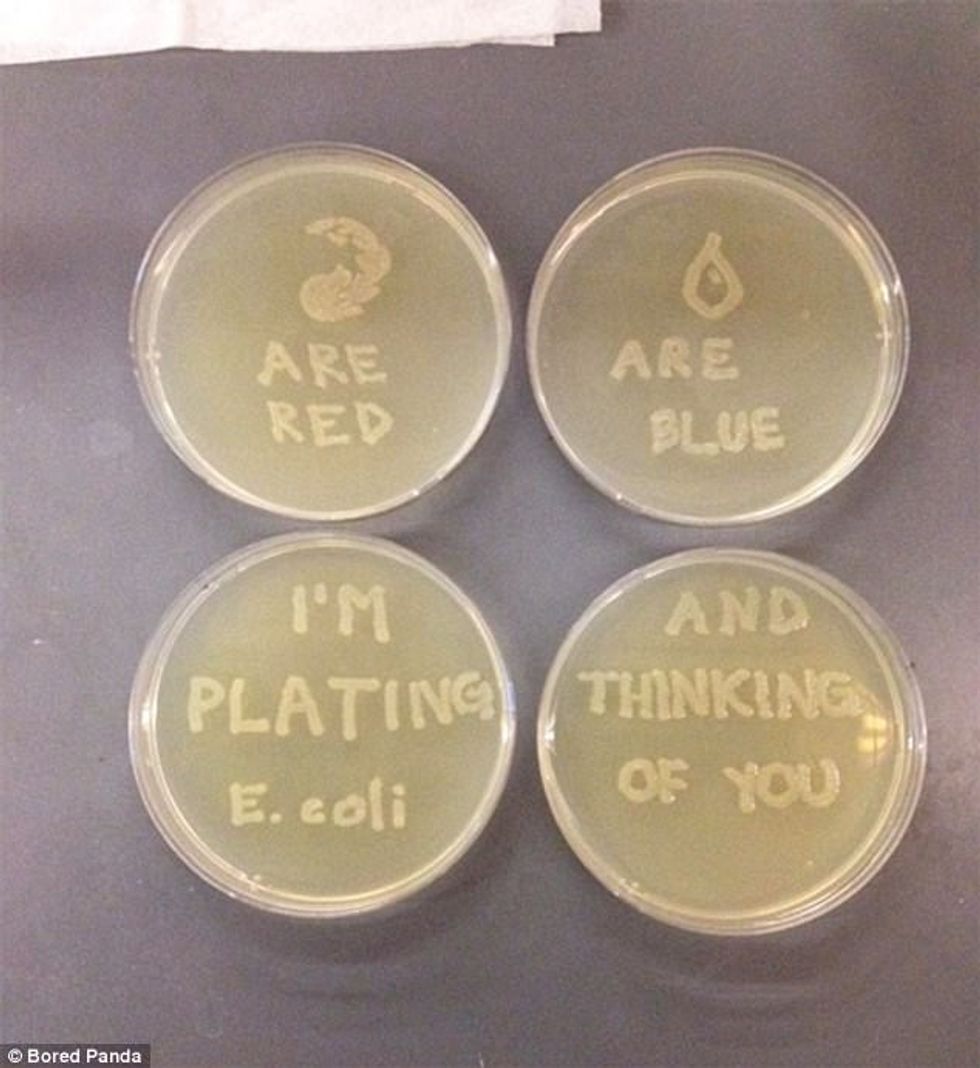
8 37

Imazhe që dëshmojnë se këto dhurata assesi nuk duhet t'ia dhuroni partnerit për Shën Valentin (Foto)

Dita e të dashuruarve po shënohet në gjithë botën, dhe çiftet tashmë i kanë dhuruar njëri-tjetrit dhuratat, duke ia shprehur haptazi dashurinë partnerëve.
Por jo gjithmonë dhuruarat që ua dhurojmë partnerëve janë të duhurat, dhe këtë gjë më së miri e dëshmon fotogaleria e publikuar më poshtë, transmeton Telegrafi.
Ata nuk kanë zgjedhur metoda për t'ia shprehur dashurinë partneres apo partnerit, por nga tendenca që të jenë sa më shumë në qendër të vëmendjes, kanë bërë disa gabime trashanike që shumë njerëz i kanë bërë të qeshin me lot.
Bored Panda ka përpiluar fotogalerinë me dhuratat më qesharake që të rinjtë ua kanë bërë partnerëve të tyre, duke shpresuar se më këtë gjest do t'i befasojnë për të mirë, por ja që ka ndodhur e kundërta. /Telegrafi/